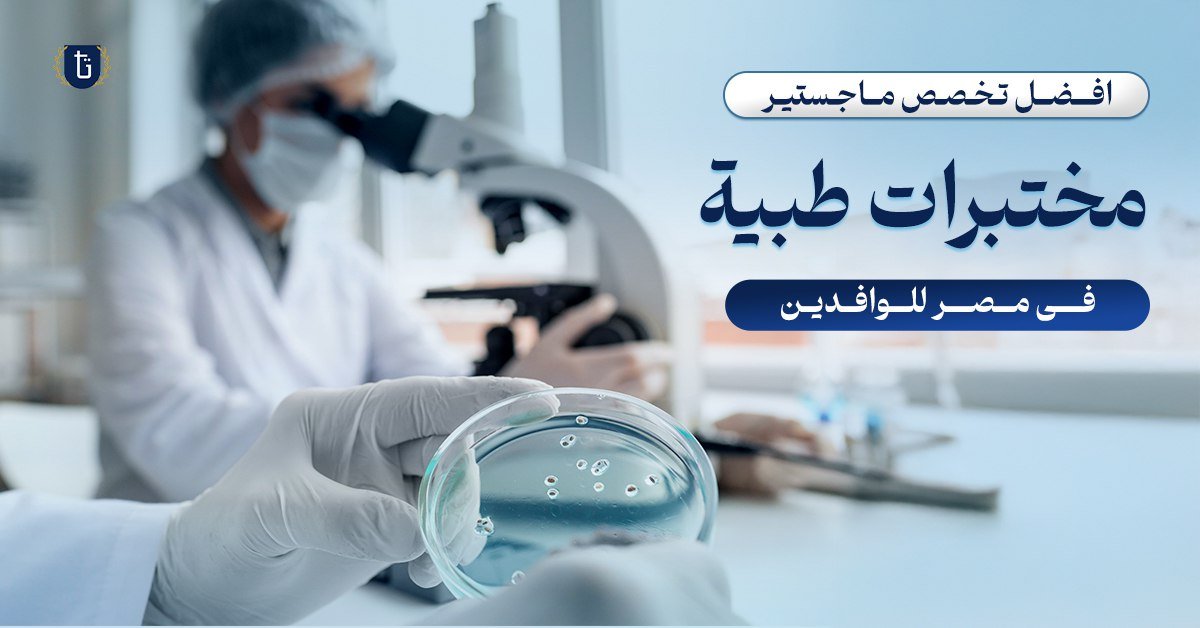
أفضل تخصص ماجستير مختبرات طبية

Contents1 مميزات دراسة كلية العلوم الصحية التطبيقية في مصر 2 هل كلية العلوم الصحية التطبيقية لها مستقبل؟ 3 أفضل الجامعات لدراسة كلية العلوم الصحية التطبيقية للوافدين4 الرسوم وشروط القبول للطلاب الوافدين في كلية العلوم الصحية التطبيقية5 تخصصات كلية العلوم الصحية التطبيقية5.1 قسم …
Contents1 أفضل كليات الذكاء الاصطناعي في مصر2 مميزات دراسة الذكاء الاصطناعي في مصر للطلاب الوافدين3 أفضل كليات الذكاء الاصطناعي في مصر بالجامعات الحكومية4 ما هي التخصصات المتاحة في كليات الذكاء الاصطناعي؟5 تكلفة دراسة الذكاء الاصطناعي في مصر للطلاب الوافدين6 هل …
Contents1 أسهل التخصصات الطبية في مصر2 أفضل تخصص طبي له مستقبل 2.1 تخصص طب الأطفال 2.2 تخصص جراحة العظام 2.3 تخصص طب الطوارئ 2.4 تخصص طب التخدير2.5 تخصص التحاليل الطبية 2.6 تخصص تقويم الأسنان 3 أفضل تخصص في الطب من حيث الراتب 4 أقل سنوات تخصص الطب 5 …
Contents1 افضل جامعة حكومية في مصر 1.1 جامعة القاهرة1.2 جامعة عين شمس1.3 جامعة المنصورة1.4 جامعة الإسكندرية1.5 جامعة حلوان2 أفضل الجامعات في مصر بالترتيب3 أفضل جامعات مصر في الطب4 رسوم الجامعات الحكومية في مصر5 كيفية التسجيل في جامعات مصر الحكومية6 الأسئلة الشائعة …
Contents1 ما هي تكاليف دراسة التمريض في مصر؟2 ما مدة دراسة التمريض في مصر؟3 ما أفضل كلية تمريض خاصة في مصر؟4 ما أرخص جامعة خاصة لدراسة التمريض في مصر؟5 كم يبلغ راتب خريج كلية التمريض في مصر؟6 ما الحد الأدنى …
Contents1 مميزات وعيوب تخصص طب الأسرة1.1 مميزات طب الأسرة1.2 عيوب طب الأسرة2 تخصص طب الأسرة في السعودية3 مستقبل تخصص طب الأسرة3.1 مجالات عمل تخصص طب الأسرة4 أبرز الجامعات المصرية لدراسة تخصص طب الأسرة5 التخصصات الدقيقة في طب الأسرة6 دليل دراسة …
Contents1 أسهل قبول ماجستير طب أسنان للطلاب الوافدين2 شروط القبول في ماجستير طب أسنان في الخارج3 شروط التقديم على ماجستير طب الأسنان للطلاب الوافدين في مصر4 لماذا تعتبر جامعات مصر أسهل قبول ماجستير طب أسنان؟5 تخصصات دراسة ماجستير طب الأسنان6 …
Contents1 أفضل تخصص ماجستير مختبرات طبية2 المستقبل الوظيفي للحاصل على ماجستير المختبرات الطبية3 أفضل الجامعات لدراسة ماجستير مختبرات طبية4 شروط التقديم في أفضل تخصص ماجستير مختبرات طبية5 تكاليف دراسة ماجستير تقنية مختبرات طبية6 عدد سنوات دراسة ماجستير المختبرات الطبية7 الأسئلة …
Contents1 أفضل تخصص في الطب للدراسة والعمل2 كيفية اختيار تخصص طبي مناسب؟3 دراسة تخصص الجراحة في الجامعات المصرية4 تخصص طب الأسرة في الجامعات المصرية5 طب الأمراض الجلدية في مصر6 تخصص النساء والتوليد7 أفضل تخصص في الطب من حيث الراتب8 أسهل …
Contents1 دراسة دكتوراه في القانون في مصر عن بعد2 مميزات الحصول على الدكتوراه في القانون والعمل داخل السعودية 3 فرص العمل والوظائف المختلفة لتخصص القانون4 الاتجاه نحو دراسة الدكتوراة في القانون في مصر5 تأثير دكتوراه القانون على الحياة المهنية 6 مجالات العمل …